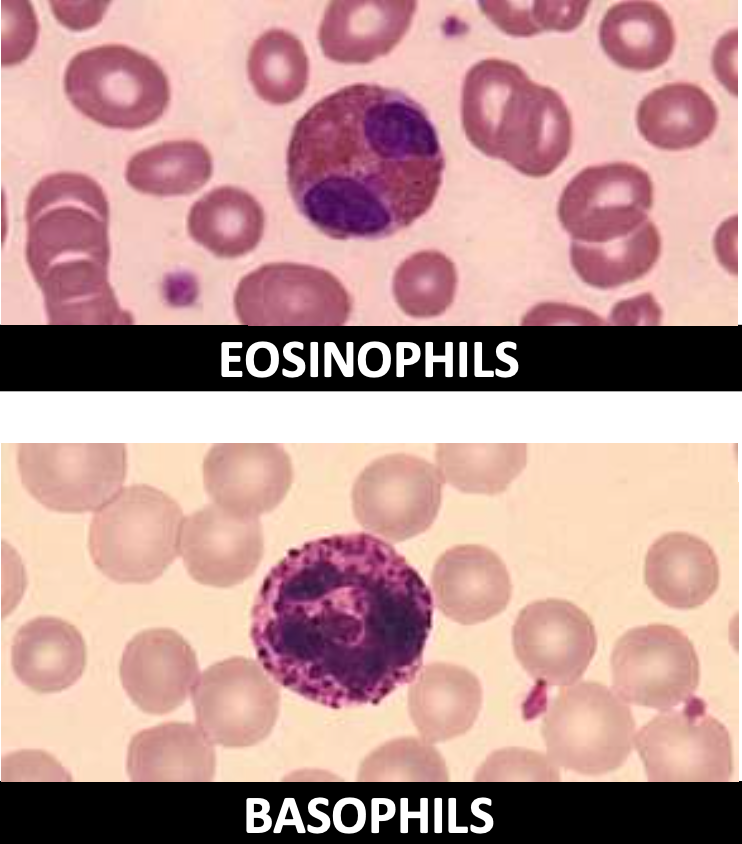
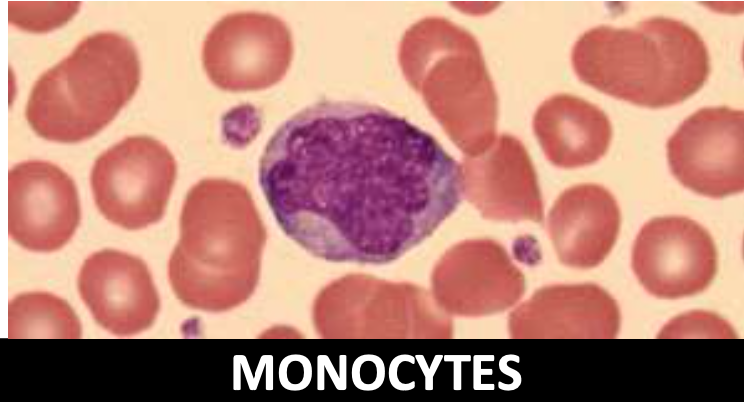
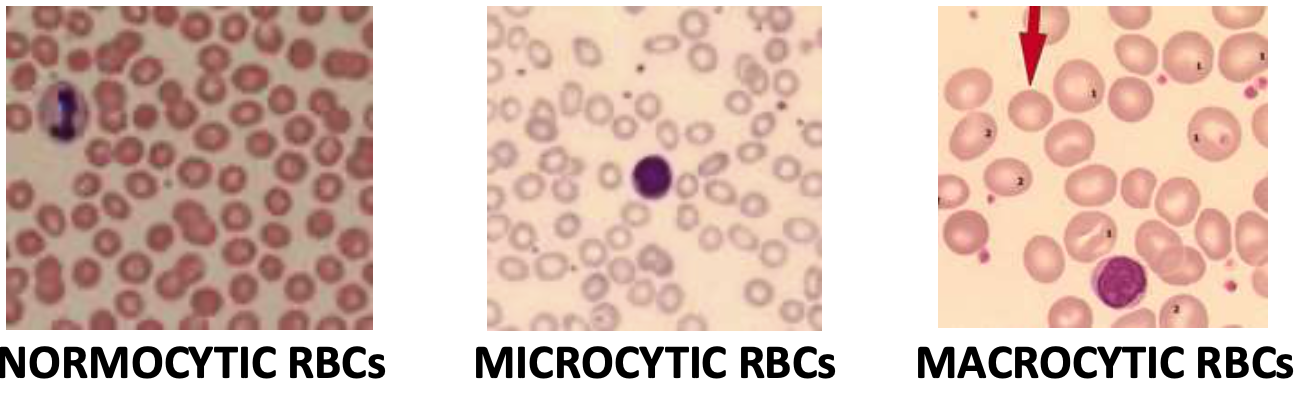
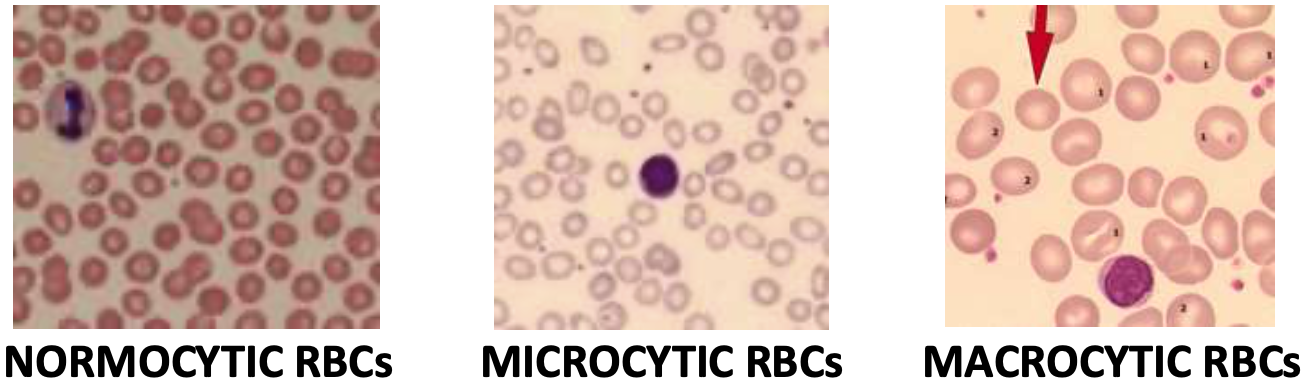
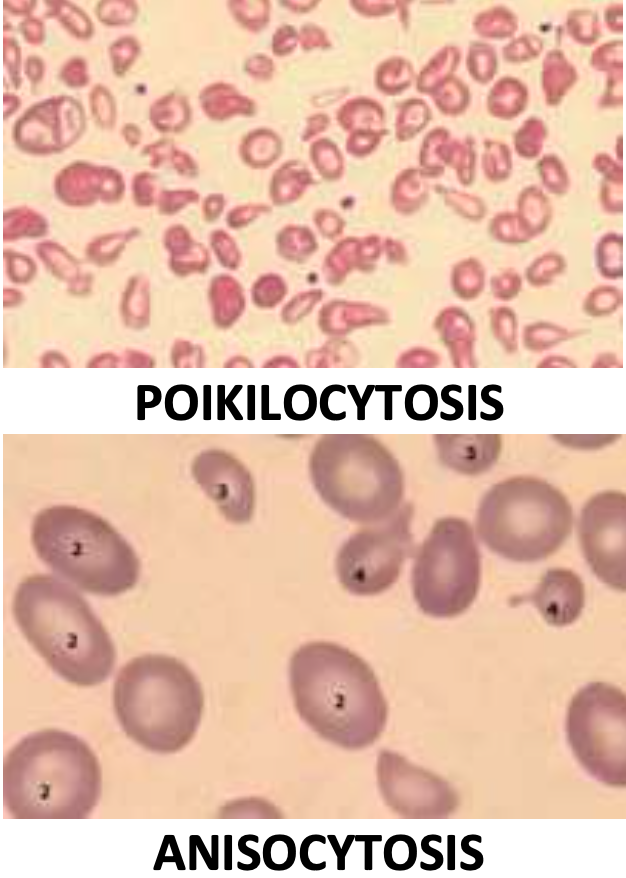
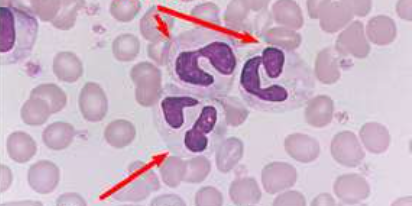
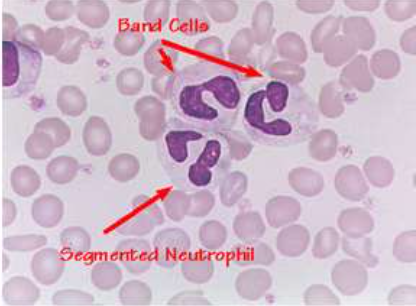
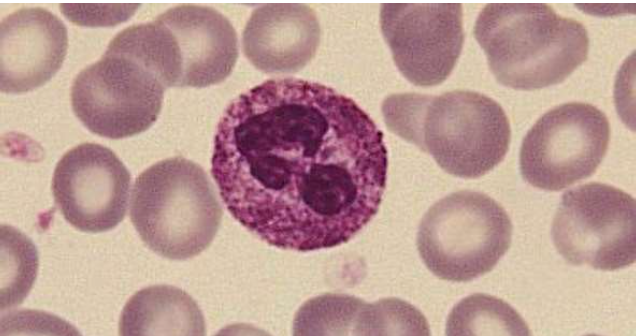
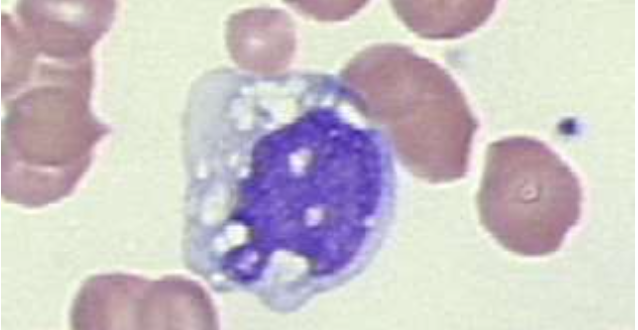
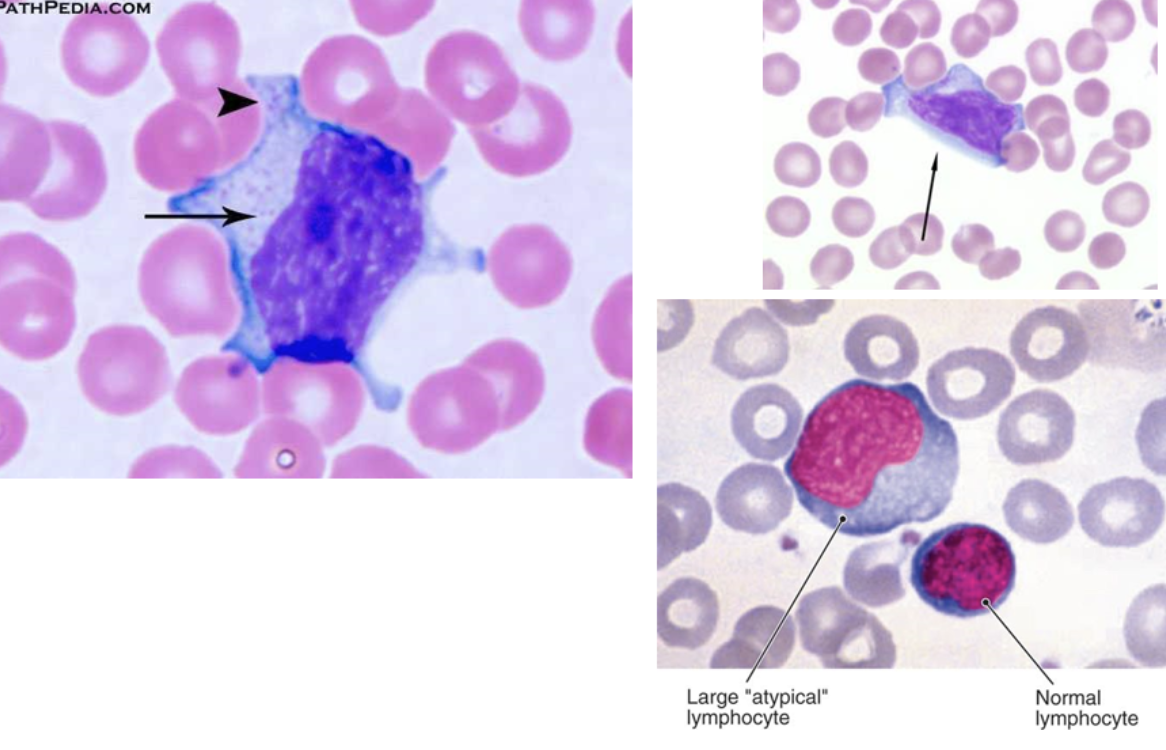
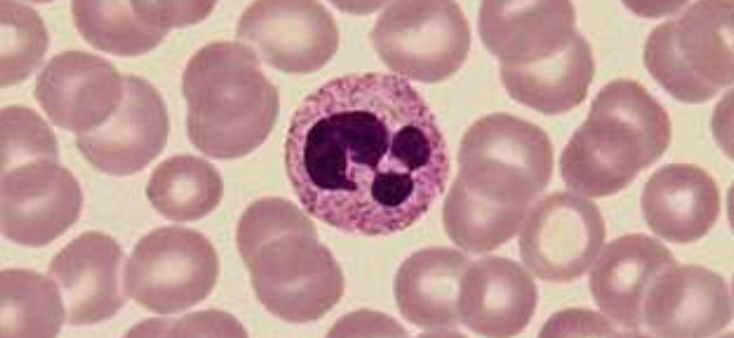
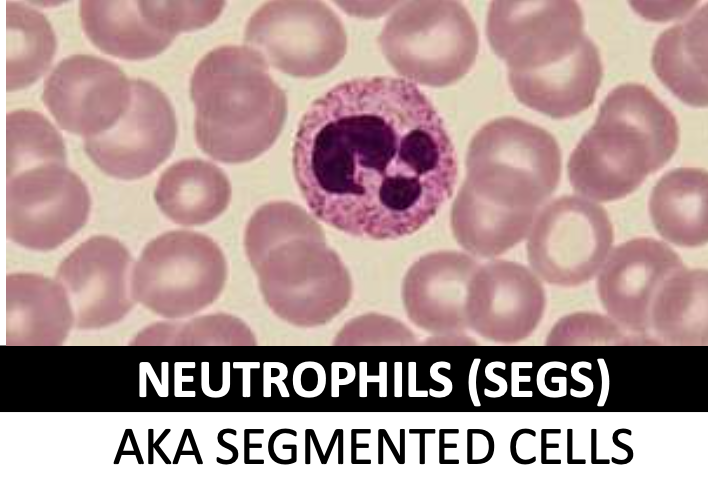
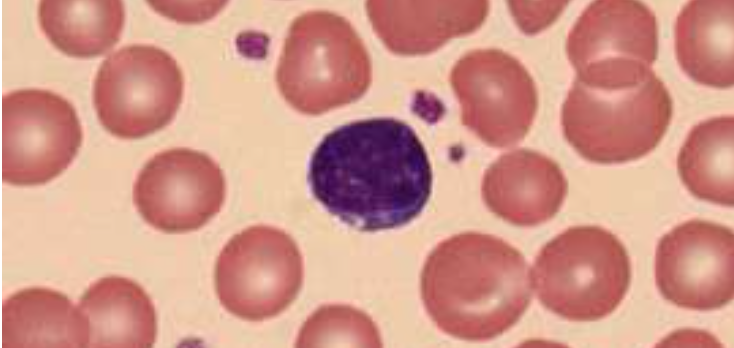
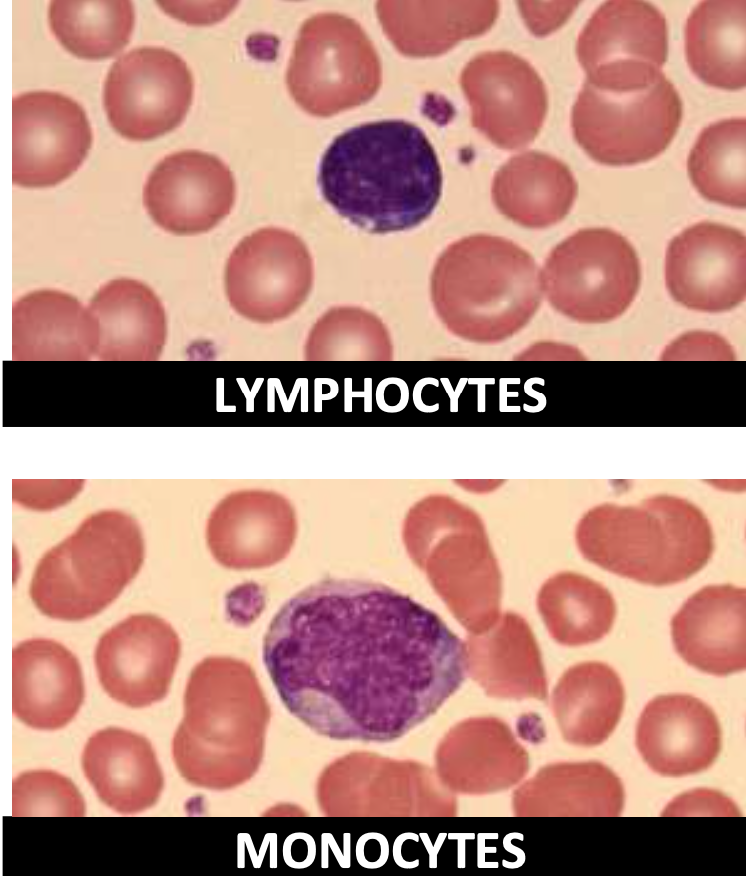

Define anemia
Decrease in total amount of red blood cells and hemoglobin in the blood
(decreased ability to carry oxygen)
What is the normal RBC count?
- men ~ 4.7 x 106/mL
- women ~ 4.2 x 106/mL
When would you see leukocytosis and when would you see leukopenia?
- Leukocytosis during acute infection (11,000/mL)
- Leukopenia during viral infections or overwhelming bacterial infections (<4,000/mL)
(normal range: 4,500-10,500/mL)
Which white blood cells are seen during an allergic disorders and or parasitic infection?
Eosinophils and basophils
When are monocytes increased?
Severe infection, Phagocytosis
What is a “band” (seen in a WBC w/diff.)?
Immature blood cells causing a “left shift”

List the white blood cells in order of abundance in the body.
- Neutrophils
- Lymphocytes
- Monocytes
- Eosinophils
- Basophils
- Bands

Thrombocytopenia is a low ______
Blood platelet count (<150,000/mL)
(“plt” = platelet)

Why is a hemoglobin count monitored?
Anemia dx or to monitor therapy for anemia
Hematocrit is a ratio of ______
Packed red blood cells : total volume of whole blood
(men: 36-48%; women: 42-52%)

Macrocytic anemia is caused by a(n) ______; whereas microcytic anemia is caused by a(n) ______.
- B12 /folate deficiency
- iron deficiency
(diagnosis of anemia is based on the red blood cell volume & hgb)
How is the average red blood cell volume measured?
(dx of anemia)
Mean corpuscular volume (MCV)
(~82-98 fL)
What is the main difference between the mean corpuscular hemoglobin (MCH) and mean corpuscular hemoglobin concentration (MCHC)?
- MCH: amount of hemoglobin / red blood cell
- MCHC: average hemoglobin concentration / red blood cells volume
What is the utility of the MCH and the MCHC?
- MCH: dx severe anemia (26-34 pg/cell)
- MCHC: monitors anemia tx (32-26 g/dL)
What does the red blood cell distribution width (RDW) tell us?
Variation of RBC sizes
(~11-14 CV)
What is the difference between poikilocytosis and anisocytosis?
- poikilocytosis: variation in size and shape
- anisocytosis: larger than normal variation (either anemia or recently released reticulocytes)

Thalassemia
toxic granulation: inflammatory rxn response of neutrophil (activated)
vacuolization: inflammatory monocyte/MF (phagocytosis)

atypical lymphocytes (activated; note the blue skirt)

Mott cell: ab-producing B cell filled w/ab vacuoles
(neutrophil present to the left)